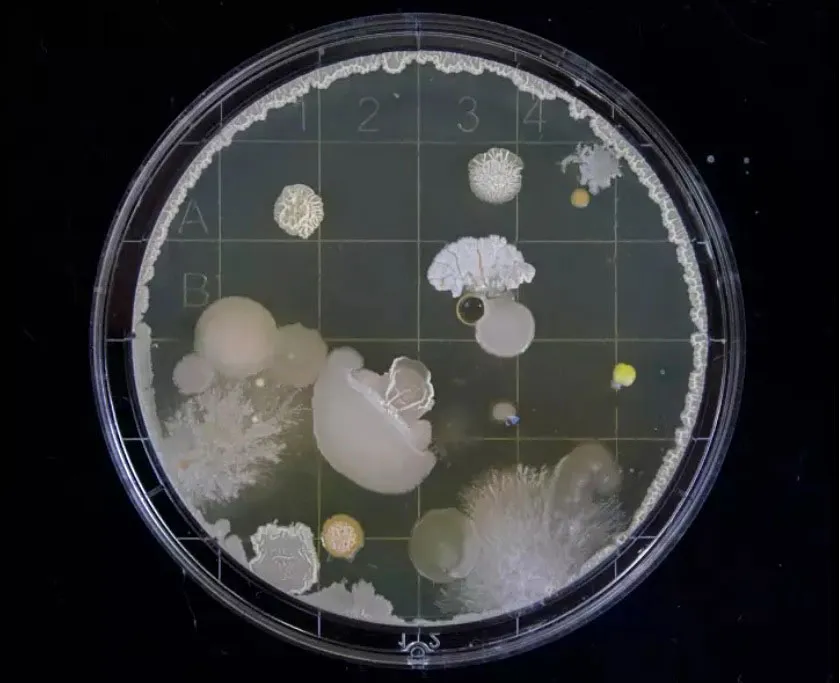
Một bản nhạc “sống” của Mikeal Hwang

Được biết đến với bí danh âm nhạc Psient, Hwang đã tìm cách cân bằng giữa nghệ thuật và khoa học: lấy cảm hứng từ nghiên cứu y sinh học để tiếp cận âm nhạc với tính nghệ thuật gắn liền với các vấn đề khoa học.
“Âm nhạc là dòng chảy miên viễn trong cuộc sống của tôi”, Hwang cho biết. Mẹ anh là ca sĩ và cha anh là người chơi kèn tuba. Anh bắt đầu học DJ ở trường đại học, cuối cùng trở thành “bán chuyên nghiệp” ở Seoul, Hàn Quốc, vào năm 2016. Nền âm nhạc điện tử ngầm đang phát triển mạnh của thành phố là nguồn cảm hứng lớn cho anh.
“Khi lấy bằng Thạc sĩ khoa học ở London, tôi đã có ý tưởng lắng nghe tế bào. Vào thời điểm đó, tôi đang tham gia vào một nghiên cứu cụ thể xem xét việc sử dụng điện như một loại thuốc - loại nghiên cứu đó khiến tôi suy nghĩ về nhiều ý tưởng khác nhau liên quan đến sự giao thoa của vạn vật”. Hwang nghĩ rằng thay vì sử dụng điện cho mục đích trị liệu, anh có thể tập trung vào việc lắng nghe các tế bào. Không thể đảm bảo nguồn tài chính, Hwang buộc phải tạm dừng sự nghiệp khoa học của mình và trở về Hàn Quốc. Nhưng tầm nhìn của anh ấy về việc lắng nghe các tế bào vẫn còn đó.
Hwang hồi tưởng: “Nó để lại một ấn tượng mạnh, đó cũng là lúc tôi nảy ra ý tưởng đơn giản hóa chủ đề, biến nó thành một biểu hiện nghệ thuật, cho phép mọi người nghe âm thanh từ một vật cực nhỏ và khiến họ nghĩ về nó giống như cách tôi đã hình dung”. Và EP Signal ra đời, một dự án giao thoa giữa sinh học, âm thanh và âm nhạc. Được hỗ trợ bởi Quỹ Văn hóa thiên đường, một tổ chức nghệ thuật có trụ sở tại Incheon, Hàn Quốc, dự án đã được triển lãm hồi tháng 5 và trưng bày cùng với các dự án nghệ thuật dựa trên công nghệ khác. Bản cài đặt nghe nhìn, ra mắt cùng lúc với Signal, là một trong những nhạc cụ duy nhất sống theo đúng nghĩa đen.
Signal bao gồm 3 thành phần: âm nhạc, đối tượng và sự thấm nhuần. Hwang cho biết: “Đầu tiên tôi thu các mẫu âm thanh về các rung động tế bào của tế bào nấm men, sau đó tôi có thể kéo giãn và thao tác để tạo ra các loại dụng cụ lai kỹ thuật số mới”. Sau đó, Hwang hợp tác với nhà thiết kế không gian và Trưởng phòng thiết kế JART Atelier Jeffrey Jehwan Kim, người đã tìm ra cách để lắng nghe sinh học và tạo ra một không gian mà mọi người có thể trải nghiệm nó. Để làm được như vậy, Hwang đã lấy cảm hứng từ những công cụ cơ bản được sử dụng trong sinh học và âm nhạc: đĩa Petri và đĩa hát vinyl.
Hwang giải thích: “Tôi lấy cảm hứng từ đĩa Petri mà chúng tôi nuôi cấy vi sinh vật và sinh học trên toàn thế giới. Nó là một công cụ cơ bản của vi sinh vật học. Tôi đã tùy chỉnh thiết kế của một bản ghi sao cho có một ngăn trống được hình thành bên trong nó, bao bọc và cấy vào đó một loại nấm men sống. Sau đó, chúng tôi chạm khắc phần trên cùng của đĩa nhựa với âm nhạc để tạo ra vật thể mà theo hiểu biết của tôi, đó là phương tiện âm nhạc sống đầu tiên. Cộng tác với Jeffrey Jehwan Kim cho phép chúng tôi tạo ra không gian này, trong đó mọi người có thể trải nghiệm âm nhạc và các đồ vật trong môi trường. Nó cho phép chúng tôi tưởng tượng mình đang ở trong tế bào của nấm men và lắng nghe những rung động của nó”.
Hwang luôn đau đáu với sứ mệnh khiến mọi người suy nghĩ về vai trò của sinh học trong văn hóa thông qua nghệ thuật: “Với nhận thức của cộng đồng, các cuộc khủng hoảng như đại dịch Covid-19 có thể đã có một ngã rẽ khác nếu mọi người hiểu rõ hơn về cách đối phó với các vi sinh vật vô hình. Mục tiêu của tôi với Jeffrey Jehwan Kim cũng là khiến mọi người suy nghĩ về việc vi sinh vật hoặc sinh học có thể đóng vai trò như thế nào trong âm nhạc. Tôi tin rằng tương lai của âm thanh là sinh học”.

























